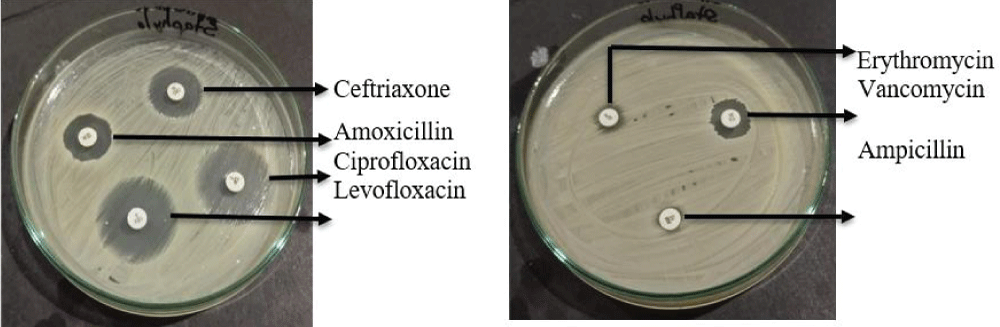

Figure 6
Identification, Molecular Confirmation, and Antibiotic Sensitivity of Bacteria Isolated from Repeat Breeder Cows in Rangpur Division
Mst. Mousumi Afroj, Md Faruk Islam, Muhammad Mamunur Roshid, Md Shanto Hossain, Md Samiul Tousif, Omiaya Azam Oishi, Subroto Sarma and Begum Fatema Zohara*
Published: 10 October, 2025 | Volume 9 - Issue 1 | Pages: 008-17
Figure 6:
Representative picture of the antibiotic sensitivity test of Klebsiella spp.
Read Full Article HTML DOI: 10.29328/journal.ivs.1001047 Cite this Article Read Full Article PDF
More Images
Similar Articles
-
Efficacies of 11% Lactoferricin and 0.05% Chlorhexidine Otological Solution compared, in the treatment of microbial otic overgrowth: A randomized single blinded studyLuisa Cornegliani*,Federico Leone,Francesco Albanese,Mauro Bigliati,Natalia Fanton,Antonella Vercelli. Efficacies of 11% Lactoferricin and 0.05% Chlorhexidine Otological Solution compared, in the treatment of microbial otic overgrowth: A randomized single blinded study. . 2017 doi: 10.29328/journal.ivs.1001004; 1: 032-041
-
In vitro antimicrobial activity of a black currant oil based shampoo versus a chlorhexidine 4% shampoo on bacteria strains isolated from canine pyoderma: A comparative studyAntonio Corona*,Paola Persico,Antonella Vercelli,Alessandro Gramenzi,Luisa Cornegliani. In vitro antimicrobial activity of a black currant oil based shampoo versus a chlorhexidine 4% shampoo on bacteria strains isolated from canine pyoderma: A comparative study. . 2020 doi: 10.29328/journal.ivs.1001021; 4: 014-017
-
Myiasis in a Backyard Pig: A Case ReportMd Niamot Ali, Mahdi Hasan, Ireen Sultana Shanta, Md Abu Choudhury, Mustafizur Rahman, Abdulla Al Mamun Bhuyan*. Myiasis in a Backyard Pig: A Case Report. . 2024 doi: 10.29328/journal.ivs.1001042; 8: 015-017
-
Intrauterine Therapy with Platelet-Rich Plasma for Persistent Breeding-Induced Endometritis in Mares: A ReviewThiago Magalhães Resende*,Renata Albuquerque de Pino Maranhão,Ana Luisa Soares de Miranda,Lorenzo GTM Segabinazzi,Priscila Fantini. Intrauterine Therapy with Platelet-Rich Plasma for Persistent Breeding-Induced Endometritis in Mares: A Review. . 2024 doi: 10.29328/journal.ivs.1001045; 8: 039-047
-
Identification, Molecular Confirmation, and Antibiotic Sensitivity of Bacteria Isolated from Repeat Breeder Cows in Rangpur DivisionMst. Mousumi Afroj,Md Faruk Islam,Muhammad Mamunur Roshid,Md Shanto Hossain,Md Samiul Tousif,Omiaya Azam Oishi,Subroto Sarma,Begum Fatema Zohara*. Identification, Molecular Confirmation, and Antibiotic Sensitivity of Bacteria Isolated from Repeat Breeder Cows in Rangpur Division. . 2025 doi: 10.29328/journal.ivs.1001047; 9: 008-17
Recently Viewed
-
Sustainable Weight Loss and Body Composition Improvement through Intensive Lifestyle Modification with Meal Replacement: A 12-Case Series with International PerspectivesNawinda Vanichakulthada*,Sunaree Pitchaiprasert,Rasintra Jaroenying,Sumalee Hantragool,Chutima Samhugkanee. Sustainable Weight Loss and Body Composition Improvement through Intensive Lifestyle Modification with Meal Replacement: A 12-Case Series with International Perspectives. Ann Clin Endocrinol Metabol. 2026: doi: 10.29328/journal.acem.1001034; 10: 17-25
-
Human Poxvirus Infections: Epidemiology, Transmission, and Clinical Features of Major Orthopoxvirus DiseasesTrisha Chakraborty,Naima Siddiqua,Subrin Shabab Trisa,Syeda Fatima Anwar,Gazi Wafa Akbar*. Human Poxvirus Infections: Epidemiology, Transmission, and Clinical Features of Major Orthopoxvirus Diseases. Int J Clin Microbiol Biochem Technol. 2026: doi: 10.29328/journal.ijcmbt.1001038; 9: 34-39
-
SARS-CoV-2 antibody response to third dose vaccination in a healthy cohortSimmi Patel*,Sarah E Wheeler,Adam Anderson,Lisa Pinto,Michael R Shurin. SARS-CoV-2 antibody response to third dose vaccination in a healthy cohort. Insights Clin Cell Immunol. 2022: doi: 10.29328/journal.icci.1001020; 6: 008-013
-
Foam Sclerotherapy versus surgery in treatment of chronic venous diseaseFatih Islamoglu*. Foam Sclerotherapy versus surgery in treatment of chronic venous disease. Arch Vas Med. 2020: doi: 10.29328/journal.avm.1001011; 4: 005-007
-
Atypical manifestations of pulmonary embolismOscar MP Jolobe*. Atypical manifestations of pulmonary embolism. Arch Vas Med. 2020: doi: 10.29328/journal.avm.1001012; 4: 008-018
Most Viewed
-
Physical Performance in the Overweight/Obesity Children Evaluation and RehabilitationCristina Popescu, Mircea-Sebastian Șerbănescu, Gigi Calin*, Magdalena Rodica Trăistaru. Physical Performance in the Overweight/Obesity Children Evaluation and Rehabilitation. Ann Clin Endocrinol Metabol. 2024 doi: 10.29328/journal.acem.1001030; 8: 004-012
-
Hypercalcaemic Crisis Associated with Hyperthyroidism: A Rare and Challenging PresentationKarthik Baburaj*, Priya Thottiyil Nair, Abeed Hussain, Vimal MV. Hypercalcaemic Crisis Associated with Hyperthyroidism: A Rare and Challenging Presentation. Ann Clin Endocrinol Metabol. 2024 doi: 10.29328/journal.acem.1001029; 8: 001-003
-
Effects of dietary supplementation on progression to type 2 diabetes in subjects with prediabetes: a single center randomized double-blind placebo-controlled trialSathit Niramitmahapanya*,Preeyapat Chattieng,Tiersidh Nasomphan,Korbtham Sathirakul. Effects of dietary supplementation on progression to type 2 diabetes in subjects with prediabetes: a single center randomized double-blind placebo-controlled trial. Ann Clin Endocrinol Metabol. 2023 doi: 10.29328/journal.acem.1001026; 7: 00-007
-
Exceptional cancer responders: A zone-to-goDaniel Gandia,Cecilia Suárez*. Exceptional cancer responders: A zone-to-go. Arch Cancer Sci Ther. 2023 doi: 10.29328/journal.acst.1001033; 7: 001-002
-
Ectopic adrenal tissue at the spermatic cordAbdallah Chaachou,Nizar Cherni,Wael Ferjaoui*,Mohamed Dridi,Samir Ghozzi. Ectopic adrenal tissue at the spermatic cord. J Clin Med Exp Images. 2022 doi: 10.29328/journal.jcmei.1001024; 6: 001-002

If you are already a member of our network and need to keep track of any developments regarding a question you have already submitted, click "take me to my Query."
























































































































































